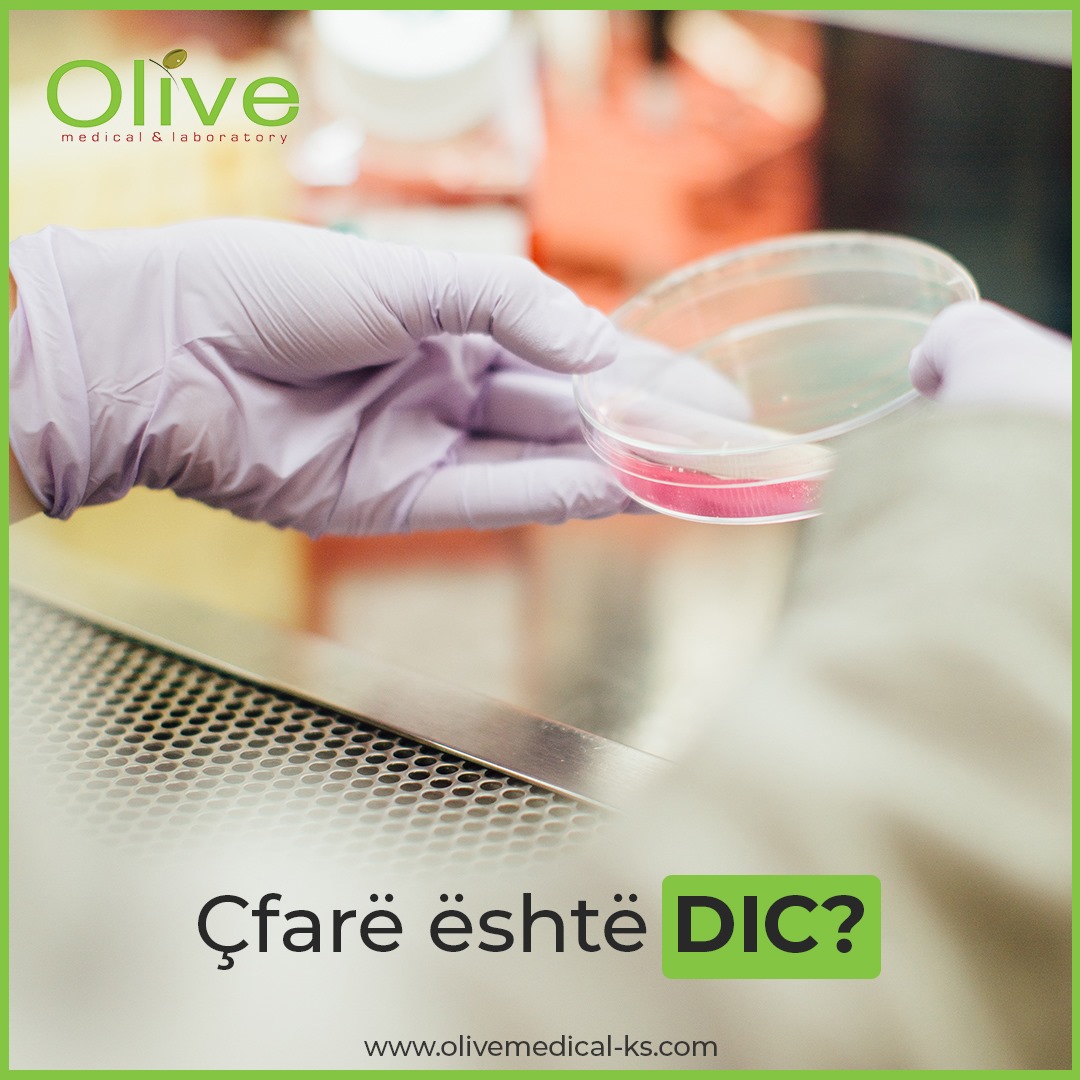

Koagulimi intravaskular i shpërndarë (DIC) është një gjendje serioze, ndonjëherë kërcënuese për jetën, në të cilën proteinat në gjak të përfshira në mpiksjen e gjakut bëhen tepër aktive. Mpiksjet e gjakut formohen në enët e vogla të gjakut në të gjithë trupin. Kjo mund të prishë rrjedhën normale të gjakut në organe të tilla si veshkat dhe mëlçia dhe mund të çojë në dështim të organeve. Për shkak se mpiksja përdor proteina të mpiksjes dhe trombocite, mund të ndodhë gjakderdhje e tepruar. Ky aktivizim anormal i mekanizmave të mpiksjes së gjakut mund të zhvillohet si rezultat i një sërë sëmundjesh dhe gjendjesh.Në mënyrë tipike, kur një person ka një dëmtim të enës së gjakut dhe ndodh gjakderdhje, trupi ndalon gjakderdhjen duke filluar një proces të quajtur hemostazë. Së pari, trombocitet ngjiten në vendin e dëmtimit dhe grumbullohen së bashku, duke formuar një prizë të lirshme. Pastaj faktorët e mpiksjes aktivizohen në mënyrë sekuenciale (shih kaskadën e mpiksjes) për të prodhuar një rrjetë fijesh fibrine që enden nëpër spinën e trombociteve dhe formojnë një mpiksje të qëndrueshme. Mpiksja qëndron në vend derisa lëndimi të shërohet, atëherë faktorë të tjerë e thyejnë mpiksjen (fibrinolizën) dhe e heqin atë. Ky proces i mpiksjes rregullohet fort. Mekanizmat e feedback-ut përshpejtojnë procesin e mpiksjes, pastaj e ngadalësojnë atë dhe kontrollojnë vëllimin e mpiksjes së prodhuar.Normalisht, trupi fillon hemostazën dhe formon një mpiksje gjaku vetëm kur është e nevojshme, d.m.th., kur ka një dëmtim dhe gjakderdhje. Trupi zbulon një pro-mpiksje, një substancë e tillë si faktori indor që lirohet nga qelizat kur ato dëmtohen. Bazuar në shkallën e dëmtimit, trupi përgjigjet duke stimuluar mpiksjen e mjaftueshme për të ndaluar gjakderdhjen dhe duke e kufizuar atë lokalisht, domethënë vetëm në vendin e dëmtimit.Me kushtet që shkaktojnë DIC, përgjigjja është e ekzagjeruar, mpiksja aktivizohet në të gjithë trupin dhe mekanizmat e kontrollit frenohen. Rezultati është formimi i një morie mpiksjesh të imëta që mund të bllokojnë enët e vogla të gjakut dhe të parandalojnë që gjaku dhe oksigjeni të shkojnë në indet dhe organet, duke çuar në dështim të shumë organeve. Mpiksja e përhapur mund të përdorë trombocitet dhe faktorët e koagulimit me një shpejtësi të shpejtë. Kjo mund ta mbingarkojë sistemin deri në atë pikë sa trupi të fillojë të rrjedh gjak, sepse trombocitet dhe faktorët e koagulimit janë shteruar. Mund të ndodhë mpiksje dhe gjakderdhje e njëkohshme. DIC mund të zhvillohet shumë shpejt, duke u bërë serioz ose edhe i rrezikshëm për jetën në një kohë të shkurtër.
DIC mund të ndodhë me kushte të tilla si:Infeksionet, veçanërisht me infeksione të rënda ose sistemike (dhe ndonjëherë që rezulton me sepsë), kryesisht bakteriale, por edhe ndonjëherë shihen me infeksione kërpudhore, virale ose parazitare, Trauma, të tilla si për shkak të një aksidenti ose djegieje të konsiderueshme, Kirurgji madhore, siç është kirurgjia bajpas kardiopulmonare, Shtatzënia dhe lindja e fëmijës, veçanërisht kur një grua ka mbajtur materiale placentare, ose një fetus që ka vdekur (lindje e vdekur), Kanceret, të tilla si leucemia akute promileocitike ose tumoret që zhvillohen brenda gjëndrave (adenokarcinoma); qelizat kancerogjene mund të lëshojnë një pro-mpiksje. Dështimi i organeve, të tilla si mëlçia, pankreasi ose dështimi i veshkave. Shkaqe të tjerë më pak të zakonshëm, të tilla si helmi i kafshimit të gjarprit, reaksioni toksik i ilaçeve, reagimi i transfuzionit të gjakut, transplantimi i organeve ose ngrirja .Shumica e rasteve të DIC që diagnostikohen zhvillohen shpejt dhe papritmas (akute), por ka raste në të cilat zhvillohet gradualisht, duke ndodhur për një periudhë më të gjatë kohore. Kjo formë kronike e DIC është e vështirë të njihet dhe diagnostikohet shumë më rrallë. Mpiksja dhe gjakderdhja e njëkohshme mund të ndodhin me DIC kronike, por në shumicën e rasteve ky është një proces i aktivizimit të vazhdueshëm të mpiksjes së gradës më të ulët dhe trupi ka kapacitet të mjaftueshëm për të kompensuar. Me DIC kronike, mbizotëron mpiksja e rritur, e jo gjakderdhja. Kanceri është një nga shkaqet më të zakonshme të shkallës së ulët të DIC.
Shenja dhe simptoma e DIC varen nga gjendja themelore, të tilla si infeksioni, trauma dhe nga ashpërsia dhe shkalla e DIC. Përveç shenjave dhe simptomave të gjendjes themelore, ato të DIC shoqërohen me gjakderdhje dhe / ose mpiksje të papërshtatshme.Gjakderdhja e rëndësishme zakonisht ndodh nga të paktën tre vende të ndryshme.Gjak në jashtëqitje ose urinë nga gjakderdhja e brendshme. Dhimbje koke dhe simptoma të tjera të shoqëruara me gjakderdhje në tru. Mavijosje dhe formimi i pikave të vogla të kuqe në lëkurë (petechiae). Gjakderdhje në vendin e plagëve, vendeve kirurgjikale, faqeve të gjilpërës ose kateterit intravenoz (IV). Gjakderdhje nga mukoza – nga hunda, mishrat e dhëmbëve, goja, etj.Mpiksja e gjakut- Simptomat varen nga vendndodhja e mpiksjes së gjakut dhe mund të përfshijnë:Simptomat që lidhen me mosfunksionimin e organeve të shkaktuara nga mpiksjet e gjakut që bllokojnë rrjedhën e gjakut dhe oksigjenin në organe të tilla si mëlçia dhe veshkat, duke çuar në dështim të mëlçisë dhe veshkave. Nxirja e lëkurës e shkaktuar nga bllokimi nga mpiksjet e gjakut dhe rrjedhja e dobët e gjakut në lëkurë. Dhimbje gjoksi, kollitje gjaku dhe / ose vështirësi në frymëmarrje të shkaktuara nga mpiksjet e gjakut në mushkëri. Dhimbje në gjoks dhe / ose një sulm në zemër i shkaktuar nga mpiksja në zemër. Dhimbje koke dhe simptoma të tjera të shoqëruara me një goditje në tru, të shkaktuara nga mpiksja në tru. Qëllimet e testimit janë të identifikojnë DIC, të vlerësojnë ashpërsinë e tij dhe të monitorojnë efektet e tij me kalimin e kohës. Nuk ka një test të vetëm që mund të përdoret për të diagnostikuar patjetër DIC. Një praktikues i kujdesit shëndetësor do të marrë parasysh shumë faktorë kur vlerëson një person që mund të ketë këtë gjendje, të tilla si shenja dhe simptoma, prania e një gjendje themelore, ekzaminimi fizik dhe historia mjekësore.Ashpërsia dhe shtrirja e DIC mund të ndryshojë me kalimin e kohës, kështu që testimi laboratorik shpesh kryhet në disa intervale për të monitoruar statusin e një personi.
Disa teste rutinë që mund të kryhen përfshijnë: CBC (numërimi i plotë i gjakut) – përfshin një numër të trombociteve; në DIC, trombocitet shpesh janë të ulta.Njollat e gjakut nga individë me DIC shpesh tregojnë zvogëlim të numrit të trombociteve dhe prani të trombociteve të mëdha dhe qelizave të kuqe të fragmentuara (skistocitet). PT (koha e protrombinës) – shpesh zgjatet me DIC pasi që konsumohen faktorë të mpiksjes. PTT (koha e pjesshme e tromboplastinës) – mund të zgjatet. D-dimer – një test që zbulon një proteinë që rezulton nga prishja e mpiksjes; shpesh është ngritur dukshëm me DIC; nëse është normale, atëherë DIC nuk ka gjasa.Fibrinogjen – një nga faktorët e koagulimit; është i ulët me DIC. Një sistem i pikëzimit të testit i zhvilluar nga Shoqëria Ndërkombëtare për Trombozën dhe Hemostazën mund të përdoret për të vlerësuar një grup të rezultateve të testit për të ndihmuar të përcaktuar nëse DIC është i pranishëm. Rezultati bazohet në rezultatet e numërimit të trombociteve, PT, D-dimer (ose produkte të degradimit të fibrinës) dhe fibrinogjenit. Sa më i lartë rezultati, aq më shumë ka të ngjarë që DIC të jetë i pranishëm.Meqenëse DIC mund të ndikojë në shëndetin dhe funksionimin e disa organeve, testimi më i përgjithshëm, siç është një panel metabolik gjithëpërfshirës (CMP), mund të urdhërohet për të vlerësuar, për shembull, statusin funksional të veshkave dhe mëlçisë. Për më tepër, disa teste të tjera mund të porositen për të ndihmuar në zbulimin e sëmundjes themelore ose gjendjes që po shkakton një person të zhvillojë DIC.
Testet jo-laboratorike- Nganjëherë kryhet një skanim me rreze x ose imazhe të tjera për të ndihmuar në lokalizimin e mpiksjes së gjakut dhe vlerësimin e organevE.
Trajtimi- Qëllimet e trajtimit për DIC janë të adresojnë gjendjen themelore që po shkakton aktivizimin e mpiksjes dhe të stabilizojnë personin e prekur. Në shumicën e rasteve, DIC do të zgjidhet kur sëmundja ose gjendja trajtohet. DIC akut zakonisht trajtohet në një ambient spitalor. Mund të ketë nevojë të merren masa mbështetëse për të adresuar gjakderdhjen dhe mpiksjen. Njerëzve që kryesisht paraqesin gjakderdhje të rëndë mund t’u jepen trombocite ose plazma të freskët të ngrirë ose kriopresipitim që përmban faktorë të koagulimit, veçanërisht kur kërkohen procedura kirurgjikale për të adresuar gjendjen themelore.
Të gjitha testet e nevojshme diagnostifikuese dhe hulumtuese mund t`i realizoni në Olive Medical & Laboratory.
Shkruan: Dr. Valbonë Blaku Specialiste e Mjekësisë Familjare, staf në Olive Medical & Laboratory